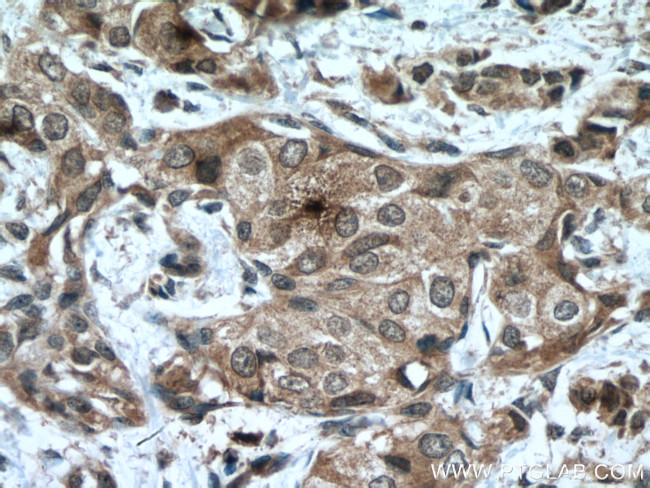
SOCS3 Antibody in Immunohistochemistry (Paraffin) (IHC (P))

Search
Proteintech
SOCS3 Monoclonal Antibody (1G2B12)
{{$productOrderCtrl.translations['antibody.pdp.commerceCard.promotion.promotions']}}
{{$productOrderCtrl.translations['antibody.pdp.commerceCard.promotion.viewpromo']}}
{{$productOrderCtrl.translations['antibody.pdp.commerceCard.promotion.promocode']}}: {{promo.promoCode}} {{promo.promoTitle}} {{promo.promoDescription}}. {{$productOrderCtrl.translations['antibody.pdp.commerceCard.promotion.learnmore']}}




Please note: We are reviewing Western blot images included in the antibody testing data in our catalog, including those provided by third parties. Unless expressly labeled or annotated as “raw-unedited”, Western blot images included in the antibody testing data in our catalog may have been edited, optimized or otherwise adjusted for presentation.
产品信息
66797-1-IG
种属反应
已发表种属
宿主/亚型
分类
类型
克隆号
抗原
偶联物
形式
浓度
规格
纯化类型
保存液
内含物
保存条件
运输条件
产品详细信息
Aliquoting is unnecessary for -20°C storage.
靶标信息
Accumulating evidence demonstrates that cytokine receptor signaling is negatively regulated by a family of Src homology 2 domain-containing adaptor molecules Termed SOCS (Suppressor of Cytokine Signaling). To date, there are eight members of SOCS family have been recognized, they are SOCS-1, 2, 3, 4, 5, 6, 7 and CIS. Structurally the SOCS proteins are composed of an N-terminal region of variable length and amino acid composition, a central SH2 domain, and a previously unrecognized C-terminal motif that we have called the SOCS box. The SOCS proteins appear to form part of a classical negative feed back loop that regulates cytokine signal transduction via a STAT-induced transcriptional mechanism. Transcription of each of the SOCS genes occurs rapidly in vitro and in vivo in response to cytokines, and once produced, the various members of the SOCS family appear to inhibit signaling in different ways.
仅用于科研。不用于诊断过程。未经明确授权不得转售。
生物信息学
蛋白别名: CIS-3; cytokine inducible SH2-containing protein 3; Cytokine-inducible SH2 protein 3; E2a-Pbx1 target gene in fibroblasts 10; MGC71791; Protein EF-10; SOCS-3; SSI-3; STAT-induced STAT inhibitor 3; Suppressor of cytokine signaling 3
基因别名: CIS3; Cish3; EF-10; Ef10; SOCS3; SSI-3; SSI3
UniProt ID: (Mouse) O35718
Entrez Gene ID: (Mouse) 12702